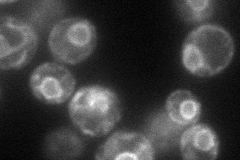
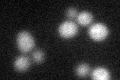
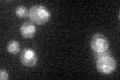

View description
Mannosyltransferase, involved in N-linked glycosylation; catalyzes the transfer of mannose from Dol-P-Man to lipid-linked oligosaccharides; mutation of the human ortholog causes type 1 congenital disorders of glycosylation
Localization:
Intensity:
Fold change:
Significance:
-
C’ GFP library in SD

ER42.09 -
N' NOP1pr-GFP in SD
ER72.7619 -
N' TEF2pr-mCherry in SD

ER10.0929 -
N' NATIVEpr-GFP in SD

ER35.9033 -
N' TEF2pr-VC and Cyto-VN in SD

#N/A0 -
C’ GFP library in SD+DTT
ER20.580.48Yes -
C’ GFP library in SD+H2O2

ER36.260.86No -
C’ GFP library in Starvation Media
ER46.571.1No -
C’ GFP library on the background of Pup2-DaMP

ER -
C’ GFP library on the background of CCT mutant

ER38.04060.903434No
